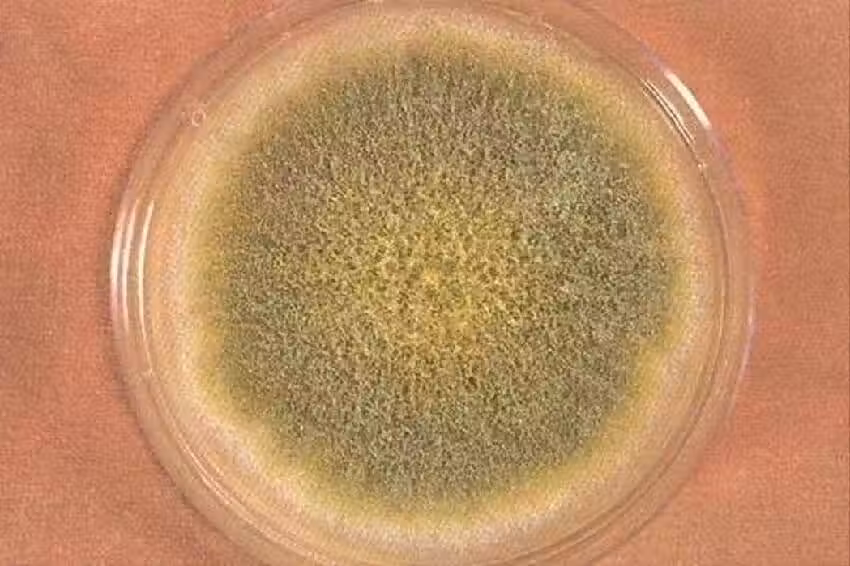

16/16
下一頁
4 種堅果攜帶毒素,致癌還傷肝,醫生道出實情:別再吃了~
16/16
黃曲黴素屬於一級致癌物,它不僅致癌級別高,而且會以慢性作用的形式,加劇肝臟的負荷,致使肝硬化和肝癌的發病風險升高 為了避免這些隱患。
我們在選購和儲存堅果時,一定要保持謹慎,優先選擇經過正規渠道檢測的產品,杜絕散裝或來源不明的堅果入食。
如果堅果出現異味、顏色異常或其他可疑情況,必須果斷丟棄,切勿因小失大,每一口健康的堅果都來源於科學的選擇,而這也是保護肝臟的重要一步。
以上內容僅供參考,若身體不適,請及時諮詢專業醫生 關於黃曲黴素您有什麼看法?
我們在選購和儲存堅果時,一定要保持謹慎,優先選擇經過正規渠道檢測的產品,杜絕散裝或來源不明的堅果入食。
如果堅果出現異味、顏色異常或其他可疑情況,必須果斷丟棄,切勿因小失大,每一口健康的堅果都來源於科學的選擇,而這也是保護肝臟的重要一步。
以上內容僅供參考,若身體不適,請及時諮詢專業醫生 關於黃曲黴素您有什麼看法?
 幸山輪 • 15K次觀看
幸山輪 • 15K次觀看 喬峰傳 • 2K次觀看
喬峰傳 • 2K次觀看 許夢可 • 2K次觀看
許夢可 • 2K次觀看 許夢可 • 310次觀看
許夢可 • 310次觀看 舒黛葉 • 380次觀看
舒黛葉 • 380次觀看 管輝若 • 3K次觀看
管輝若 • 3K次觀看 幸山輪 • 300次觀看
幸山輪 • 300次觀看 管輝若 • 1K次觀看
管輝若 • 1K次觀看 喬峰傳 • 340次觀看
喬峰傳 • 340次觀看 管輝若 • 2K次觀看
管輝若 • 2K次觀看 舒黛葉 • 780次觀看
舒黛葉 • 780次觀看 舒黛葉 • 540次觀看
舒黛葉 • 540次觀看 花伊風 • 220次觀看
花伊風 • 220次觀看 花伊風 • 230次觀看
花伊風 • 230次觀看 管輝若 • 830次觀看
管輝若 • 830次觀看 喬峰傳 • 5K次觀看
喬峰傳 • 5K次觀看 管輝若 • 9K次觀看
管輝若 • 9K次觀看 喬峰傳 • 610次觀看
喬峰傳 • 610次觀看 喬峰傳 • 1K次觀看
喬峰傳 • 1K次觀看 幸山輪 • 60次觀看
幸山輪 • 60次觀看 花伊風 • 200次觀看
花伊風 • 200次觀看 舒黛葉 • 410次觀看
舒黛葉 • 410次觀看 呂純弘 • 4K次觀看
呂純弘 • 4K次觀看 管輝若 • 730次觀看
管輝若 • 730次觀看






















